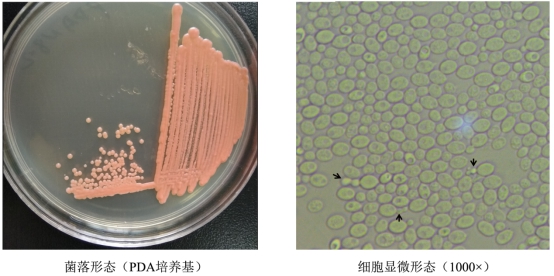

(食品·化工学院 通讯员 郭壮)近日,国际期刊International Journal of Systematic and Evolutionary Microbiology刊发了我校为第一单位和唯一通讯单位的论文Halobasidium xiangyangense gen. nov., sp. nov., a new xylose-utilizing yeast in the family Cystobasidiaceae, isolated from the pickling sauce used to make Datoucai, a high-salt fermented food(doi: 10.1099/ijsem.0.003119),该论文报道了食品科学技术学院·化学工程学院传统发酵食品团队从中国地理标识产品——襄阳大头菜中分离且以“襄阳”命名的1株酵母新属Halobasidium xiangyangense(襄阳耐盐担子酵母)。本研究由我校传统发酵食品团队与内蒙古农业大学乳品生物技术与工程教育部重点实验室国家自然科学基金优秀青年科学基金获得者孙志宏研究员团队合作完成,我校张振东博士为通讯作者,郭壮博士为第一作者,赵慧君博士和我校教师参与内蒙古农业大学联合培养的博士研究生王玉荣为署名作者。
新物种的发现和命名有着严格的程序和规定,需经过国际菌物命名委员会(Nomenclature Committee for Fungi,NCF)认定,且发表在指定的系统分类学学术期刊上,一旦发表就意味着该分类单元得到了国际学术研究领域的认可。H. xiangyangense从发现、鉴定到文章发表历时2年半,共完成了系统发育关系、生理生化特性、基因组测序和细胞成分等近20项指标的验证,菌株分别在韩国典型培养物保藏中心(Korean Collection of Type Cultures, KCTC)、广东省微生物菌种保藏中心(Guangdong Microbial Culture Collection Center, GDMCC)和中国典型培养物保藏中心(China Center for Type Culture Collection, CCTCC)进行保藏,ITS间区、18SrRNA、26SrRNA和基因组序列均在美国国立生物技术信息中心NCBI (National Center for Biotechnology Information)进行登记。
襄阳大头菜是中国四大名腌菜之一,襄阳市现有大头菜生产企业30余家、家庭作坊近百家,年产值逾2亿元。研究发现H. xiangyangense具有较高的耐盐性且可高效利用木糖,该物种的发现为后续襄阳大头菜腌制过程中膜醭形成和腌制周期过长等产业化问题的解决提供了理论指导,同时作为第一个以“襄阳”命名的新物种,该物种的发现亦在一定程度上提升了襄阳的国际知名度。
审稿人:汤尚文